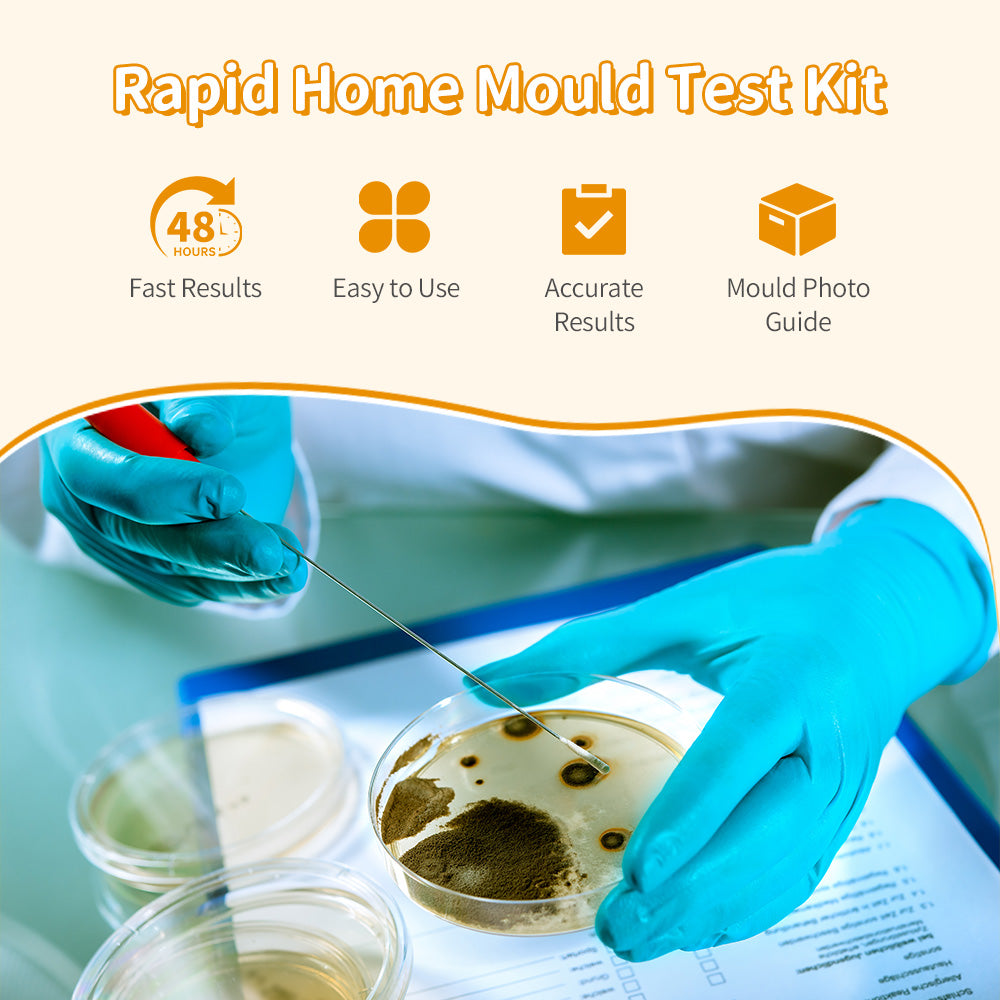

Ezytest
EzyTest Mould Test Kit (1 Test) – 48hr Home Mould Detection for Air & Surfaces + A/C Vent Sampling – Includes Mould Photo Identification Guide
EzyTest Mould Test Kit (1 Test) – 48hr Home Mould Detection for Air & Surfaces + A/C Vent Sampling – Includes Mould Photo Identification Guide
Couldn't load pickup availability
Product Description
Find hidden mould fast — even before you can see it
The EzyTest Mould Test Kit helps you quickly check for mould in your home or workplace by capturing airborne spores or surface contamination. Simply prepare the Petri dish, sample your chosen area, and observe growth after 48 hours (some moulds may take longer). Includes a Mould Photo Guide to help you compare common mould types.
Why you’ll love it
48-hour results: Observe mould growth after incubation (daily checks recommended).
Easy to use: No complicated steps — pour, set, sample, wait.
Test multiple locations: Air sampling, surface swab sampling, and air conditioner vent sampling.
Mould Photo Identification Guide: Helps you understand what you’re seeing.
Where to use it
Bathrooms, bedrooms, kitchens, wardrobes, window frames/condensation areas, carpets, walls, and near A/C vents — anywhere you suspect dampness, musty smells, or visible spotting.
What’s in the box (1 test per kit)
1 × Petri dish
1 × Reagent vial
1 × Cotton swab
1 × Instruction leaflet + Mould Identification Guide
How it works (3 simple steps)
Prepare: Pour the reagent into the Petri dish, replace lid, gently rotate to coat evenly. Let it set for at least 1 hour.
Sample:
Air: Expose to air for 1 hour, then close.
A/C vent: Place near vent and run A/C for 10 minutes, then close.
Surface: Swab the area, then lightly rub the swab across the gel surface.
Incubate & Check: Keep at room temperature and observe after 48 hours (check daily).
Safety & handling
Wash hands before/after use. Avoid touching the gel surface. Use gloves/mask if sampling visibly mouldy areas. Store unused kits in the refrigerator. Ideal incubation temperature: 24–28°C.
Note: This kit is for screening and educational use. If you have serious health symptoms or extensive mould, consider professional advice.
Share